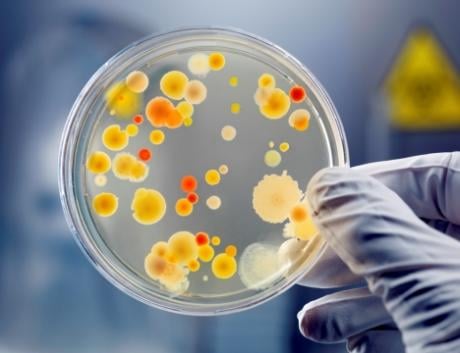

Дұрыс тамақтанбау әдеттері жасөспірімдердің денсаулығына қалай әсер етеді?

Көбінесе жасөспірімдер тамақтану жөніндегі ұсынымдарды сақтамайды, бұл денсаулықтың нашарлауына әкелуі мүмкін. Балалар мен жасөспірімдер арасында тамақтану әдеті, мысалы, жемістер мен көкөністерді аз жеу, көбінесе тәтті сусындарды ішіп, тәттілерді жеу әдеті […]
Халықаралық сарапшылар «COVID-19 бақылау орталығы» веб-қосымшасын пайдалану тәжірибесімен бөлісті

2020 жылы 9 желтоқсанда Орталық Азия хабы ұйымдастырған онлайн кездесуде халықаралық сарапшылар «COVID-19 бақылау орталығының» веб-қосымшасын пайдалану тәжірибесімен бөлісті. Іс-шараға Қазақстан, Кырыгызстан және Түркіменстан өкілдері қатысты. «COVID-19 бақылау орталығының» веб-қосымшасын […]
ДДСҰ-ның ЖЕА-ны бақылау және алдын алу жөніндегі Еуропалық офисінің өкілдерімен өткен кеңес (Мәскеу қ.)

2020 жылы 9 желтоқсанда ДДСҰ-ның ЖЕА-ны (НИЗ) бақылау және алдын алу жөніндегі Еуропалық офисінің (Мәскеу қ.) және ҚР ДСМ Қоғамдық денсаулық сақтау ұлттық орталығының өкілдерімен онлайн кеңес өтті. ҚДСҰО тарапынан […]
Коронавирустан емделгендер қандай талаптарды орындауы керек

НҰР-СҰЛТАН. ҚазАқпарат – Биыл коронавирусты қайта жұқтыру деректері әлем елдерінде тіркеліп жатқандығы туралы ақпарат тарағаны белгілі. Сонымен қатар қараша айында ҚР Денсаулық сақтау министрлігі өкілдері індетті қайта жұқтыру дерегі Қарағанды […]
ҚДСҰО Оперативті орталықтардың қызметкерлерін оқытуды жалғастыруда

Қоғамдық денсаулық сақтау ұлттық орталығы (бұдан әрі — ҚДСҰО) «Бағдарламалық қамтамасыз ету және COVID-19 кезіндегі оперативті орталықтардың жұмысы» тақырыбында біліктілікті арттыру курстарын өткізуді жалғастыруда. Ағымдағы жылдың 2-5 желтоқсан аралығында ҚДСҰО […]
ЖИТС-тің емі жоқ, сондықтан оның алдын алу керек – Жұмабек Бекенов

НҰР-СҰЛТАН. ҚазАқпарат – Ешбір елде ауруды жеке-дара жеңу мүмкін емес, себебі бәрі бір-бірімен байланысты. Бұл туралы Орталық коммуникациялар қызметінде өткен онлайн брифингте ҚР Денсаулық сақтау министрлігінің Қоғамдық денсаулық сақтау ұлттық […]
Бекенов: СПИД-тің алдын алуда күш біріктіру қажет

Нұр-Сұлтан, BAQ.KZ тілшісі. Бұл туралы бүгін ҚР Президенті жанындағы Орталық коммуникациялар қызметі алаңында өткен онлайн брифинг барысында ҚР ДСМ ҰДСО жұқпалы аурулардың алдын алу департаментінің директоры Жұмабек Бекенов айтты. Бүгінгі […]
1 желтоқсан — Қазақстан Республикасының тұнғыш президенті күні

Құрметті қазақстандықтар! Сіздерді 1 желтоқсан – Қазақстан Республикасы Тұңғыш Президенті күні мерекесімен шын жүректен құттықтаймыз! Осы салтанатты күні баршаңызға мықты денсаулық, бейбітшілік пен жаңа жетістіктер тілейміз.
1 желтоқсан – Дүниежүзілік ЖИТС-ке қарсы күрес күні

Дүниежүзілік ЖИТС-ке қарсы күрес науқаны шеңберінде ҚР ДСМ Қоғамдық денсаулық сақтау ұлттық орталығының телестудиясында Нұр-Сұлтан қаласы ЖИТС-тың алдын алу және оған қарсы күрес орталығы директорының орынбасары С.Б. Мусинамен сұхбат өтті. […]
Зерттеуге қатысуыңызды сұраймыз!

Жиналған деректерді талдау қорғасынмен уланудан денсаулықты қорғау мен бақылаудың берік және тұрақты жүйесінің іргетасын қалауға көмектеседі. Қорғасынның әсерінің алдын алуға болады. ҚДСҰО +7747 183 03 19 Қуаныш Алимбетов ЮНИСЕФ + […]
173 сарапшы химиялық қауіпсіздікті қамтамасыз ету регламентін талқылады

2020 жылы 25-27 қарашада «Химиялық қауіпсіздікті қамтамасыз ету бөлігінде халықаралық және ұлттық регламенттерді қолдану» тақырыбында халықаралық тренинг онлайн режимде өтті, тренингке Ресей, Беларусь және Қазақстаннан 173 сарапшы қатысты. Аталған іс-шараны […]
Қазақстанның төрт қаласында балалардың қанындағы қорғасын мөлшерінің деңгейіне зерттеу жүргізіледі

ҚР ДСМ Қоғамдық денсаулық сақтау ұлттық орталығы БҰҰ Балалар қорымен (ЮНИСЕФ) бірлесіп, балалар ағзасындағы қорғасын мөлшерін зерттеуге бастама көтерді. Зерттеу қоршаған ортаның ластануының артуына және қауіптілігіне байланысты жағдайды зерттеуге және […]
ҚР ДСМ Қоғамдық денсаулық сақтау ұлттық орталығы «Салауатты Ресей қалалары» форумына қатысты

2020 жылы 25 қарашада ҚР ДСМ Қоғамдық денсаулық сақтау ұлттық орталығының Қоғамдық денсаулықты нығайту орталығының басшысы Жазира Ембердиева «Ресей салауатты қалалары» форумына қатысты. Іс-шарада ол «Қазақстанның салауатты қалалары мен аймақтарының […]
ҚР ДСМ ҚДСҰО-да халықаралық тренинг өтеді

ҚР ДСМ Қоғамдық денсаулық сақтау ұлттық орталығы «Химиялық қауіпсіздікті қамтамасыз ету бөлігінде халықаралық және ұлттық регламенттерді қолдану» атты халықаралық онлайн – тренингке қатысуға шақырады. 2020 жылы 25-27 қараша аралығында Федералдық […]
Аязды күні маска тағу дұрыс па? Қыста коронавирустан сақтану жолдары

Коронавирустың жаңа толқыны қысқы уақытқа сәйкес келуі мүмкін екендігі елімізде әлдеқашан болжанып, дайындық күшейтілді. Қазіргі уақытта күн сайынғы вирус жұқтыру қарқыны артып келеді. Денсаулық сақтау министрлігі Санитарлық-эпидемиологиялық бақылау комитетінің мәліметінше, […]
Сарапшылар балалар арасындағы артық салмақ пен семіздіктің алдын алу мәселесін талқылады

Бүгін ҚР Денсаулық сақтау министрлігінің қолдауымен Денсаулық сақтауды дамытудың 2020-2025 жылдарға арналған мемлекеттік бағдарламасы аясында балалар арасында артық салмақ пен семіздіктің алдын алу жөніндегі Ұлттық стратегия жобасын талқылау бойынша онлайн […]
СOVID – 19 мәселелері бойынша ДДСҰ өкілдерімен кездесу өтті

2020 жылы 18 қарашада ҚР ДСМ Қоғамдық денсаулық сақтау ұлттық орталығында басшылық (директор Д.А.Көбжасаров, директордың бірінші орынбасары Б.С.Жүсіпов) пен Қоғамдық денсаулық сақтау саласындағы ТЖ жөніндегі Оперативті орталығының мамандары ДДСҰ өкілдері […]
Пневмониядан қалай қорғануға болады

НҰР-СҰЛТАН. ҚазАқпарат — 12 қараша Пневмонияға қарсы күрес күні ретінде атап өтіледі, деп хабарлайды ҚазАқпарат ҚР ДСМ Қоғамдық денсаулық сақтау ұлттық орталығына сілтеме жасап. 2009 жылы Дүниежүзілік денсаулық сақтау ұйымы […]
Пневмония белгілері қандай және қалай оның алдын алуға болады?

Бүгін Дүниежүзілік пневмонияға қарсы күрес күні. Соған орай, Қоғамдық денсаулық сақтау ұлттық орталығы оның алдын алу жолдарын ұсынады. 2009 жылы Дүниежүзілік денсаулық сақтау ұйымы ЮНИСЕФ-пен бірлесіп «Пневмонияның алдын алу және […]
Пневмонияның алдын алу үшін не істеу керек

2009 жылы Дүниежүзілік денсаулық сақтау ұйымы ЮНИСЕФ-пен бірлесіп, «Пневмонияның алдын алу және оған қарсы күрес жөніндегі жаһандық іс-қимыл жоспарын» жариялады. Биыл он бірінші жыл қатарынан 12 қарашада әлемдегі балалар өліміне […]
12 қараша — Дүниежүзілік пневмонияға қарсы күрес күні

2009 жылы Дүниежүзілік денсаулық сақтау ұйымы ЮНИСЕФ-пен бірлесіп, «Пневмонияның алдын алу және оған қарсы күрес жөніндегі жаһандық іс-қимыл жоспарын» жариялады. Биыл он бірінші жыл, 12 қарашада бүкіл әлемдегі балалар өліміне […]
ҚДСҰО Оперативті орталықтардың қызметкерлерін оқытуды жалғастыруда
Қоғамдық денсаулық сақтау ұлттық орталығы (бұдан әрі — ҚДСҰО) короновирус инфекциясы кезінде Оперативті орталықтардың жұмысында бағдарламалық қамтамасыз етуді игеру мақсатында «COVID-19 кезінде бағдарламалық қамтамасыз ету және Оперативті орталықтардың жұмысы» тақырыбы […]
ҚДСҰО Петропавл қаласының №3 қалалық емханасының қызметкерлері үшін біліктілікті арттыру курсын өткізді

Қоғамдық денсаулық сақтау ұлттық орталығы (бұдан әрі — ҚДСҰО) 21-25 қазан аралығында Петропавл қаласының №3 қалалық емханасының қызметкерлері үшін «COVID—19 коронавирус инфекциясының эпидемиологиясы» тақырыбында біліктілікті арттыру курсын өткізді. Мақсаты […]
Жусан COVID-19 емдеуге көмектеспейді

Көктемде Мадагаскарда COVID-19 жусан тұнбаларымен сәтті емделетіні туралы ақпарат бұқаралық ақпарат құралдарында жарық көрді. Бірақ бұл әдістің тиімділігі туралы ғылыми дәлелдер жоқ. Дегенмен, бұл хабарлама әлі күнге дейін әлеуметтік желілерде […]
Тамақ мифологиясы: майлы тамақ өкпеге пайдалы. Бұл рас па?

Әлеуметтік желілерден майлы тағам өкпеге пайдалы деген газетте жарық көрген мақаланың суретін кездестіруге болады. Жазбаның авторы дәрігерлер адамдарды майды шамадан тыс тұтыну қаупі деп ескерте отырып, қателеседі дейді. Бұл мәлімдеме […]
ҚДСҰО Қарағанды облысы Денсаулық сақтау басқармасының Оперативті орталығының қызметкерлеріне арналған біліктілікті арттыру курсын өткізді

Қоғамдық денсаулық сақтау ұлттық орталығы (бұдан әрі – ҚДСҰО) Қарағанды облысы Денсаулық сақтау басқармасының Қарағанды қ. №4 емхана мен Қоғамдық денсаулық сақтау қызметінің оперативті орталығының қызметкерлеріне арналған «COVID-19 коронавирус инфекциясының […]
ҚДСҰО өз телестудиясын іске қосты

ҚДСҰО өз телестудиясын іске қосты Біз қоғамдық денсаулық сақтау мәселелері, оның ішінде Қазақстандағы КВИ эпидемиологиялық ахуал туралы айтатын боламыз. Коронавирус инфекциясынан қалай қорғануға болады, сондай-ақ ЖРВИ, тұмаудың алдын алу, вакцинация […]
10 қазан – Дүниежүзілік психикалық денсаулық күні

Бүкіләлемдік денсаулық қорғау ұйымының пайымдауынша, психика саулығы дегеніміз адам ақыл-ойының, физикалық және эмоционалдық дамуының толыққанды жетілуіне ықпал етуші күй болып табылады💆🏼♀️
ҚДСҰО қызметкерлері коронавирус пандемиясына қарсы күреске қосқан үлесі үшін марапатталды

ҚДСҰО қызметкерлері коронавирус пандемиясына қарсы күреске қосқан үлесі үшін марапатталды 2020 жылы 9 қазанда ҚР ДСМ Қоғамдық денсаулық сақтау ұлттық орталығында ҚДСҰО қызметкерлерін Covid-19 пандемиясына қарсы күрестегі жемісті еңбегі үшін […]
Еңбек адамының мүддесін қорғау мен кәсіподақ қозғалысын дамытудағы ұзақ жылғы жемісті еңбегі үшін

Кәсіподақтар күні мерекесін ұлықтау мақсатында Кәсіподақ федерациясы ҚР ДСМ Қоғамдық денсаулық сақтау ұлттық орталығы Жұқпалы аурулардың алдын алу департаментінің директоры Жұмабек Елтекұлы Бекеновті Еңбек адамының мүддесін қорғау мен кәсіподақ қозғалысын […]
Қазақстан мен көршілес елдердегі балалардың тамақтану әдеті

Қазақстанда COSI зерттеуді ҚР ДСМ Қоғамдық денсаулық сақтау ұлттық орталығы әр 3 жыл сайын жүргізеді. Зерттеу мақсаты — барлық балалар үшін салауатты орта құру, дұрыс тамақтануды насихаттау және тамақтану жағдайына […]
Сапалы тағам, жағымды эмоция. Ерте қартаймау үшін есте ұстау қажет негізгі 5 кеңес

50-60 жастан кейін ағзада физиологиялық өзгерістер болады: зат алмасу баяулайды, ішектің жұмысы әлсірейді, ферменттердің белсенділігі төмендейді. ДСМ Қоғамдық денсаулық сақтау ұлттық орталығы денсаулықты нығайтып, қажыр-қайратты ұзақ жылдар бойы сақтауға қажет […]
1 қазан — Халықаралық қарттар күні

ҚР ДСМ «Қоғамдық денсаулық сақтау ұлттық орталығы» ШЖҚ РМК денсаулықты қалай сақтап, ұзақ жылдар бойы қажырлы болып қала беру керектігі жөніндегі қарапайым кеңестерімен бөліседі. Денені шынықтырып, белсенді болу. Таза ауада […]
Қартаю жылдамдығын қалай баяулатуға болады – маман кеңесі

ҚР ДСМ «Қоғамдық денсаулық сақтау ұлттық орталығы» ШЖҚ РМК денсаулықты сақтап, ұзақ жылдар бойы қажырлы болу үшін не істеу керектігі туралы кеңестерімен бөлісті. Денені шынықтырып, белсенді болу. Таза ауада жиі […]
Ұзақ жылдар бойы белсенді болу жөніндегі бірнеше қарапайым кеңес – мамандар

НҰР-СҰЛТАН. ҚазАқпарат – Денсаулық министрлігіне қарасты «Қоғамдық денсаулық сақтау ұлттық орталығы» РМК мамандары денсаулықты қалай сақтап, ұзақ жылдар бойы белсенді болып қала беру керектігі жөніндегі бірнеше қарапайым кеңеспен бөлісті, деп […]
Балалар арасында суицидті алдын алу жөнінде онлайн отырыс өтті

ҚР ДСМ Қоғамдық денсаулық сақтау ұлттық орталығының сарапшылары «Нұр Отан» ХДП, Балаларды қорғау жөніндегі кеңес ұйымдастырған онлайн-кеңеске қатысты. Бұл шарада балалар арасында суицидтің алдын алу, психологтардың жұмысы, жалпы Қазақстан Республикасында […]
Менингит – негізгі белгілері және алдын алу жолдары
Менингит – бас миы қабықтарының серозды қабыну түрi бойынша өтетiн және вирусты инфекция тудыратын қабынуы. Қоздырғышы граммтеріс диплококк, менингококк. Менингиттің қоздырғышы тыныс алу, жөтелу кезінде,сөйлегенде және түшкіргенде ауа арқылы таралады. […]
Тұмаудың алдын алудың тиімді жолы қандай? Маман кеңесі

Тұмауға қарсы вакцинация жүкті әйелдер үшін дұрыс шешім. Вакцинаның балаға қаупі жоқ. Алайда, жүктілік мерзімі 14 аптаға жетпесе, екпе салдыруға болмайды. ДСМ Қоғамдық денсаулық сақтау ұлттық орталығы тұмаудың алдын алу […]
Тұмауға қарсы вакцина кімдерге бірінші кезекте салынады

НҰР-СҰЛТАН. ҚазАқпарат – Ұлттық денсаулық сақтау орталығының қоғамдық денсаулықты нығайту орталығының жетекшісі Жазира Ембердиева тұмауға қарсы екпе жасау тәртібін түсіндірді, деп хабарлайды ҚазАқпарат тілшісі. «Жіті респираторлық-вирустық инфекциясына тоқталсақ, бұл тұрғыда […]
Тұмауға қарсы вакцинаның бағасы қанша теңге болатыны айтылды

Бұл туралы ОКҚ-де өткен онлайн баспасөз конференциясына қатысқан Ұлттық денсаулық сақтау орталығы инфекциялық аурулардың алдын алу департаментінің директоры Жұмабек Бекенов айтып берді, деп хабарлайды BAQ.KZ. Оның сөзінше тәуекелдік топ бар. […]
Қазақстанда 15 қыркүйектен бастап тұмауға қарсы екпе басталады

Қазақстанда КВИ-ге байланысты тұмау екпесі 15-ші қыркүйектен басталады. Екпе салу Алматы, Нұр-Сұлтан, Павлодар қаласында 10-шы қыркүйектен басталды. Тұмауға қарсы екпені еліміздегі 2 миллион адам тегін салдырады. «Елімізде тәуекелдік топтар бар. […]
Осы жылғы эпидемиологиялық маусымға алаңдаушылық бар — Бекенов

«Тұмауға қарсы екпені алу өте маңызды. Себебі, тұмау мен коронавирустың таралуына алаңдаушылық танытып отырмыз». Бұл сөзді Ұлттық денсаулық сақтау орталығы инфекциялық аурулардың алдын алу департаментінің директоры Жұмабек Бекенов айтты, — […]
Химиялық заттарды қауіпсіз басқару
Химиялық заттарды қауіпсіз басқару химиялық заттарды қарқынды өндіру, пайдалану және қалдықтарының пайда болуы жағдайында қоршаған орта мен адамдардың денсаулығын қорғаудың маңызды шарты болып табылады. Химиялық заттар мен қалдықтарды қауіпсіз басқару […]
Маусымдық тұмаудың алдын алу шаралары қандай

НҰР-СҰЛТАН. ҚазАқпарат – Күз және қыс мезгілдерінде адамдар арасында вирустық инфекциялық аурулар жиілейді. Осы орайда ҚР ДСМ Қоғамдық денсаулық сақтау ұлттық орталығы жұқпалы аурулардың алдын алу департаментінің директоры Жұмабек Бекенов […]
Бір орында отырып жұмыс істеу: денсаулықты сақтауға арналған 5 кеңес

Бір орында отырып жұмыс істеудің денсаулыққа кері әсер ететіні құпия емес: омыртқа қисаяды, мойынның қан тамырлары білеуленеді, бұл орталық жүйке жүйесінің әртүрлі ауруларына алып келеді. Ең дұрысы, өзімізге қосымша уақыт […]
Дамир Көбжасаров: елімізде инфекцияға қарсы иммунитеті бар азаматтар саны артып келеді

Қазақстандықтардың 60%-да коронавирусқа қарсы иммунитеті болғанда пандемияны тоқтата аламыз. Бұл туралы Newsroom+Ақпарат агенттігі ҚазАқпарат порталына сілтеме жасап хабарлайды. «Елімізде инфекцияға қарсы иммунитеті бар азаматтар саны артып келеді. Қазақстандықтардың 60%-ы қажетті […]
Қазақстандықтардың 60%-да коронавирусқа қарсы иммунитеті болғанда пандемияны тоқтата аламыз. Бұл туралы ҚазАқпарат тілшісіне берген сұхбатында ҚР ДСМ Қоғамдық денсаулық сақтау ұлттық орталығының директоры Дамир Көбжасаров айтты.

Қазақстандықтардың 60%-да коронавирусқа қарсы иммунитеті болғанда пандемияны тоқтата аламыз. Бұл туралы ҚазАқпарат тілшісіне берген сұхбатында ҚР ДСМ Қоғамдық денсаулық сақтау ұлттық орталығының директоры Дамир Көбжасаров айтты. «Елімізде инфекцияға қарсы иммунитеті […]
Адамдардың 60%-да коронавирусқа қарсы иммунитеті болғанда пандемияны тоқтата аламыз — Дамир Көбжасаров

НҰР-СҰЛТАН. ҚазАқпарат – Қазақстандықтардың 60%-да коронавирусқа қарсы иммунитеті болғанда пандемияны тоқтата аламыз. Бұл туралы ҚазАқпарат тілшісіне берген сұхбатында ҚР ДСМ Қоғамдық денсаулық сақтау ұлттық орталығының директоры Дамир Көбжасаров айтты. «Елімізде […]
Еcте сақтау қабілетін жақсартуға арналған қарапайым әдістер

1. Қиялыңызды қосыңыз Сандарды естерінде сақтай алатындар көбіне санды өсімдік, жануар және жансыз заттар түрінде елестетеді. Мысалы, екі санын аққу, бір санын жол жиегіндегі бағана, алты санын құлып және т.с.с. […]
ҚР ДСМ Қоғамдық денсаулық сақтау ұлттық орталығының жанындағы төтенше жағдайлар жөніндегі оперативті орталыққа корей компаниясының өкілдері келді

Korea telecom көшбасшы копаниясы бастамашыл тобының өкілдері ақпаратты-коммуникациялық технологияларды (АКТ) қолдана отырып, COVID-19 күресуге арналған ЗТ Корей стратегиялық бағдарламасымен («Тест», «Қадағалау», «Емдеу») таныстыру үшін Нұр-Сұлтан қ. келді. ҚР ДСМ Қоғамдық […]
Қоғамдық денсаулық сақтау ұлттық орталығы Қоғамдық денсаулықты нығайту орталығының басшысы Жазира Ембердиева елдегі карантинді жеңілдету қауіпсіздік шараларды ұмытуға себеп емес екенін еске салады

– Көпшілік қатаң карантин аяқталысымен, сауда-ойын-сауық орталықтарына, дүкендерге, сұлулық салондарына ағылады. Алайда карантин режимін ешуақытта естен шығаруға болмайды. Әлеуметтік қашықтық, кемінде 1,5-2 метр, қолды кемінде 20 секунд жиі жуу, санитайзермен […]
Бруцеллез деген не және ол несімен қауіпті?

Бруцеллез – бұл полиорганды патологиялармен және хронизациялау қабілеттілігімен сипатталатын зоонозды инфекция. Бруцеллездың маңызды патогенетикалық құрамдаушысы аллергиялық реактивтілік болып табылады. Бруцеллёздың қоздырушылары Brucella тұқымдасындағы бактерияларға жатады, олардың арасында жеке сегіз түрінің […]
Көзіңізді сақтаңыз

Көзді жарықтан қорғаңыз. Ультракүлгін сәуле көздің торқабықшасын бұзады. Жазда күннен қорғайтын көзілдірікті қолданыңыз. Құрамында «А» витамині бар тағамды көбірек тұтыныңыз. Ол сәбізде, балықта және қызыл етте бар. Сондай-ақ, «А» витамині […]
Тұмау маусымы жақындап келеді

Күн біртіндеп салқындап, адамға суық тию қаупі артып келеді. Оның алдын алу үшін денсаулықты нығайтып, иммунитетті күшейту қажет. ҚР ДСМ Қоғамдық денсаулық сақтау ұлттық орталығының сарапшысы Әсем Күмісбаева ұсынған қарапайым […]
Ұйқының аздығы организміңізге қалай әсер етеді

▶️Тағамның нашар қорытылуы Ұйқының қанбауы қабынбалы аурулардың және қышқылдық рефлекстің пайда болуына әкеледі. ▶️Есте сақтау қабілетінің нашарлауы Ұйқының аздығы есте сақтау процестеріне және миымыздың жаңа ақпаратты өңдеуіне әсер етеді, бұл, […]
Артериялық гипертониияны, жүректің ишемиялық ауруын және қант диабетін анықтауға арналған скрининг

Қазақстан 2008 жылдан бастап көптеген елдердің қатарында негізгі инфекциялық емес ауруларды, о.і. қан айналымы жүйесінің ауруларын және қант диабетін ерте анықтауға арналған скринингтік тексерулерді енгізді. Бұл аурулар ұзақ уақытқа созылады […]
Білім және денсаулық: дене шынықтыру және спорт әлеуеті

Денсаулықты нығайтуға ықпал ететін қазақстандық мектептердің ұлттық үйлестірушісі Ақбота Әбілдина ҚР Білім және ғылым министрлігінің жыл сайынғы тамыз конференциясының «Дене шынықтыру» секциясына қатысты. Онлайн-режимдегі конференция «Білім және денсаулық: дене шынықтыру […]
COVID-19 жағдайына байланысты күйзелісті және үрейді жеңуге болады

Күйзелісті жеңудің дұрыс немесе бұрыс әдістері болмайтыны және оны әр адам әртүрлі әдістермен жеңетіні есіңізде болсын. Қазіргі жағдайда қорқыныштан арылып, өз жан тыныштығыңызды сақтаудың бірнеше әдістері бар. ҚР ДСМ Қоғамдық […]
«Жүгіруге ешуақыт кеш емес». Денсаулық елшісі Марат Жыланбаевтың кеңесі

Жүгіру – денсаулық сақтау, артық салмақ тастау және таза ауада көп уақыт өткізу үшін таптырмайтын әдіс. Материалды Денсаулық сақтау министрлігі Қоғамдық денсаулық сақтау ұлттық орталығы ұсынды. Марат Жыланбаев – әлемнің […]
Қарбызды қалай таңдау керек?

ҚР ДСМ Қоғамдық денсаулық сақтау ұлттық орталығының инфекциялық емес аурулар қауіп-қатері факторларының мониторингі бөлімінің басшысы Насима Жүнісова кеңес береді: Бөлінген, жарылған, соғылған қарбыздарды сатып алмаңыз. Өйткені, тәтті сұйықтықтың мол болуы, […]
Денсаулық туралы жаңа Кодексте екпе туралы не айтылған?

ҚР ДСМ Қоғамдық денсаулық сақтау ұлттық орталығы Жұқпалы аурулардың алдын алу департаментінің директоры Жұмабек Бекенов маңыздыларын атап өтті:🔊 🔘Жаңа кодексте міндетті және ерікті профилактикалық егу туралы толықтай айтылған. Міндетті егу […]
Баланың күн режимін ұйымдастырыңыз

ҚР ДСМ Қоғамдық денсаулық сақтау ұлттық орталығының сарапшысы Әсем Күмісбаева жазғы демалыстардан кейін баланың үйреншікті күн режиміне қалай қайта ұстану керек екені туралы былай дейді: ✅Мектеп жасындағы баланың шамамен 8 […]
Денсаулық елшісі Марат Жыланбаевтың жүгіруді жаңа бастағандарға арналған кеңестері

Жүгіруді бастау ешкімге ерте де емес, кеш те емес. Бұл – денсаулық сақтау, артық салмақ тастау және таза ауада көп уақыт өткізу үшін таптырмайтын әдіс. Марат Жыланбаев – әлемнің жеті […]
Коронавирустан кейінгі оңалу. Ағзаны сауықтыруға арналған 5 пайдалы кеңес

Коронавирусты инфекцияның басты ерекшелігі – гипоксия, яғни оттегінің жетіспеуі болып табылады. Бұл қорқыныш пен депрессия тудырады. Денсаулық сақтау министрлігі Қоғамдық денсаулық сақтау ұлттық орталығы, қоғамдық денсаулықты нығайту орталығының басшысы Жазира […]
Коронавирус инфекциясымен ауырған адамдарға арналған 5 пайдалы кеңес

ҚР ДСМ Қоғамдық денсаулық сақтау ұлттық орталығы, қоғамдық денсаулықты нығайту орталығының басшысы Жазира Ембердиева коронавирусты инфекциямен ауырған адамдарға мына кеңестерді ұсынады. 1. Күн сайынғы тыныс алу гимнастикасы. Дем алуды – […]
Дүниежүзілік баланы емізу апталығы

Жыл сайын 1 тамыздан бастап 7 тамызға дейін әлемдегі емшектегі балалардың денсаулығын нығайту мақсатында емізуді насихаттауға бағытталған Дүниежүзілік баланы емізу апталығы өткізіледі. 1997 ж. бастап Қазақстанда емізуді қорғау және қолдау […]
Қазақстандағы COVID-19 бойынша жаңартылған статистиканың алғашқы нәтижесі туралы

COVID–19 және пневмонияға шалдыққан науқастар туралы мәлімет барынша ашық болу үшін Қазақстан Республикасы Денсаулық сақтау министрлігі 18 шілдеден бастап статистикалық деректерді есепке алу мен қалыптастырудың жаңа тәсілдерін анықтады. ДДСҰ-ның Еуропалық […]
Темекі өнімдерінің жаңа түрлері және олардың Қазақстанда таралуы

Қазіргі таңда Қазақстанда дәстүрлі темекіге «қаупі аз» және «түтінсіз» балама ретінде ұсынылатын темекі өнімдерінің жаңа түрлері кеңінен таралды. Шындығында, олардан бөлінетін элементтер, әдетте денсаулыққа зиян келтіретін улы заттардан тұрады. Никотинді […]
Сібір жарасы дегеніміз не?

Жұқпалы ауру, оның қоздырғышы – сібір жарасының таяқшасы (Bacillus anthracis). Микроорганизмнің ерекшелігі — топырақта 20 жылға дейін тіршілік ету қабілетін сақтай алатын споралардың пайда болуы. Инфекция көзі — үй жануарлары […]
28 шілде – Дүниежүзілік гепатитке қарсы күрес күні
Жыл сайын, 28 шілдеде әлемнің көптеген елдерінде, соның ішінде Қазақстанда да халыққа гепатит түрлерінің қаупі туралы ақпарат беруді арттыруға және азаматтарды диагностика, вакцинация сияқты профилактикалық шаралар қабылдауға тартуға бағытталған Дүниежүзілік […]
28 шілде — Дүниежүзілік гепатитке қарсы күрес күні
Жыл сайын, 28 шілдеде әлемнің көптеген елдерінде, соның ішінде Қазақстанда да халыққа гепатит түрлерінің қаупі туралы ақпарат беруді арттыруға және азаматтарды диагностика, вакцинация сияқты профилактикалық шаралар қабылдауға тартуға бағытталған Дүниежүзілік […]
Трансмайлар – қауіптілігі және зияны.

Трансмайлар – жоғары температурада қайта өңдеу процесінде қанықпаған (өсімдік) майларда пайда болатын түрлендірілген молекулалар. Трансмайлар табиғатта да аз мөлшерде кездесіп жатады, бірақ майларды индустриялық өңдеу кезінде олардың үлесі 20-50% — […]
Қолдың ластануынан болатын сары ауру

Жыл сайын 28 шілдеде вирустық гепатит туралы хабардар болуды арттыру мақсатында Дүниежүзілік гепатитке қарсы күрес күні атап өтіледі. 2020 ж. «Болашағымыз гепатиттен таза болу керек» ұранымен өтеді және аналар мен жаңа туған нәрестелер арасында В гепатитінің (ВГВ) алдын алуға […]
«Сары аурудан сақтаныңыз!» Маман кеңесі

Қоғамдық денсаулық сақтау ұлттық орталығы вирустық гепатиттің себептері мен алдын алу жолдарын түсіндіреді. Вирустық гепатит – әртүрлі вирустардан туындайтын жұқпалы аурулардың үлкен тобы. Ол бауырдың зақымдануымен сипатталады, дегенмен әрқайсының бір-бірінен […]
Екпе салдыртпаған бала мектепке бара ала ма?

Мемлекет басшысы Қасым-Жомарт Тоқаев «Халық денсаулығы және денсаулық сақтау жүйесі туралы» Қазақстан Республикасының жаңа кодексіне қол қойған болатын. Соның ішінде бала құқығы да қарастырылған. Бұл жайында ҚР ДСМ Қоғамдық денсаулық […]
Тырысқақ ауруы туралы не білуіміз керек?

Тырысқақ (лат. cholera) – антропонозды жіті ішек жұқпасы, Халықаралық медициналық – санитарлық ережелерге сәйкес карантинді жұқпаларға жатқызылады. Жұқпа таралуының жалғыз көзі – ауру адам немесе тырысқақ бойынша қолайсыз аймақтан келген қоздырғышты нәжіс […]
Жіті ішек инфекциясының алдын алу

Ішек инфекциясы – біріншіден ас қорыту жолын зақымдайтын жұқпалы аурулардың бір тұтас тобы. Микроорганизмдердің бірнеше тобы: бактерия, вирус және қарапайымдылар жіті ішек инфекцияларының себебі болып табылады. Инфекция көзі – науқас […]
Денсаулық кодексінде вакцинациялау міндетті және ерікті деп бөлінеді

Халық денсаулығы және денсаулық сақтау жүйесі туралы Кодекстің жаңа редакциясына енгізілген өзгерістердің бірі вакцинациялау туралы. Вакцинациялау, яғни инфекциялық ауулардың алдын алуда қолданылатын тиімді құрал. Жаңа Кодексте вакцинациялау міндетті және ерікті […]
Қоғамдық орындарда темекі өнімдерін сатуға тыйым салынды

Темекі өнімдерін, оның ішінде кальянға арналған темекіні, темекіні қыздыруға арналған жүйелерді, электрондық темекі мен темекі өнімдерін өндіруге арналған сұйықтықты сату шектелген: жиырма бір жасқа дейінгі адамдар; темекі бұйымының ашық қорабынан […]
Жіті ішек инфекциясының алдын алу
Ішек инфекциясы – біріншіден ас қорыту жолын зақымдайтын жұқпалы аурулардың бір тұтас тобы. Микроорганизмдердің бірнеше тобы: бактерия, вирус және қарапайымдылар жіті ішек инфекцияларының себебі болып табылады. Инфекция көзі – науқас […]
Ішек инфекциясынан қалай сақтануға болады? Маман кеңесі

Қоғамдық денсаулық сақтау ұлттық орталығы қауіпті инфекцияның себептері мен алдын алу жолдарын түсіндіреді. Ішек инфекциясы – бірінші кезекте ас қорыту жолын зақымдайтын жұқпалы аурулардың тобы. Оның пайда болуына негізінен микроағзалардың […]
13 шілде — Қазақстанда коронавирус құрбандарының Ұлттық аза тұту күні

2020 жылдың 13 шілдесі Қазақстанда коронавирус құрбандарын Ұлттық аза тұту күні. ⠀ Кәсіби борышын адалдықпен атқарып, халықтың денсаулығын сақтау жолында өз өмірлерін қиған дәрігерлерді мәңгілік есімізде сақтаймыз. ⠀ Туған-туыстары мен […]
Ресей делегациясы ҚР ДСМ Қоғамдық денсаулық сақтау ұлттық орталығы жанындағы ТЖ жөніндегі Оперативті орталықта болды

6 шілде күні Қазақстан астанасына арнайы рейспен Ресей денсаулық сақтау министрлігінің және Роспотребнадзордың дәрігерлері келген болатын. Көрші ел мамандары мемлекет аумағында коронавирустың өршуіне қарсы күресте қазақстандық әріптестеріне практикалық және консультациялық […]
Qoldau 24/7 медициналық қызметтер жайлы ақпарат алу мобильді қосымшасы

Qoldau 24/7: медициналық қызметтерді жайлы және қауіпсіз алу. Qoldau 24/7 мобильді қосымшасы МӘМС мәселелері бойынша азаматтардың өтініштерін қабылдау және өңдеу үшін құрылған. Сонымен қатар жиі қойылатын сұрақтарға: сақтандыру мәртебесі, төлемдер […]
Мектепке дейінгі мекемелерге арналған онлайн-семинар

Маусым айының соңында COVID-19 алдын алу және бақылау бойынша негізгі хабарламалар мен іс-қимыл жөнінде онлайн-семинарлар басталды. Оқыту мақсаты – мектепке дейінгі мекемелердің, балабақшалардың басшылығы мен медицина персоналын карантин кезінде және […]
Үй жағдайында коронавируспен қалай күресуге болады?

Қазіргі уақытта коронавируспен үй жағдайында күресетіндердің қатары көп. Науқастардың 80%-ында вирустың жеңіл формасы болғандықтан, олар госпитализациялауды қажет етпейді және үйде емделеді, – деп хабарлайды NewsRoom+ тілшісі Stan.kz ақпарат агенттігіне сілтеме […]
Коронавируспен үй жағдайында қалай күресуге болады

Қазір коронавируспен ауырған адамдардың дені үйде емделіп жатыр. Олар (80%-ға дейін) жеңіл түрде ауырып жатқандықтан, жұқпалы аурулар стационарына жатқызу талап етілмейді және үй жағдайында емделуге болады. Дегенмен, науқас жағдайының нашарлауына […]
Қоғамдық денсаулық сақтау ұлттық орталығы қашықтан жұмыс істеу тәртібіне көшті

СOVID -19 таралуына жол бермеу мақсатында 2020 жылы 10 маусымнан бастап ҚР ДСМ Қоғамдық денсаулық сақтау ұлттық орталығы қашықтан жұмыс істеу тәртібіне көшті. ҚДСҰО барлық қызметкерлері үйден бұрынғы тәртіп бойынша […]
Коронавируспен үй жағдайында қалай күресуге болады? Сізге арналған 8 кеңес

Қазір коронавируспен ауырған адамдардың басым бөлігі үйде емделуде. Коронавирус жұқтырғандардың 80 пайызға жуығы жеңіл түрде ауырып жатқандықтан, жұқпалы аурулар стационарына жатқызу талап етілмейді. Ал олардың үй жағдайында емделуге болатыны – […]
Жас балалар арасында артық салмақ пен семіздіктің алдын алу мәселесі талқыланды

ҚР ДСМ Қоғамдық денсаулық сақтау ұлттық орталығында «Жас балалар арасында артық салмақ пен семіздіктің алдын алу бойынша ЮНИСЕФ-тің бірлескен бағдарламасын іске асыруда қоғамдық денсаулық сақтау қызметін нығайту» тақырыбында online режимінде […]
Науқастар саны 27 мыңнан асты

Президент жанындағы Орталық коммуникациялар қызметінің ақпараттық алаңында коронавирус жағдайына байланысты баспасөз мәслихаты өтті. Іс-шараға Денсаулық сақтау министрлігі Қоғамдық денсаулық сақтау ұлттық орталығы Жұқпалы аурулардың алдын алу департаментінің директоры Жұмабек Бекенов, […]
Қазақстандықтар коронавирусты жеңіл өткере бастады — ДСМ

Денсаулық сақтау министрінің лабораториялық қызмет жөніндегі кеңесшісі Жанар Сүлейменова коронавирус генетикалық тұрғыдан өзгеретінін және қазақстандықтар коронавирусты жеңіл өткере бастағанын айтты, — деп хабарлайды Tengrinews.kz тілшісі. «Қазір, әрине, коронавирус жұқтырып, симптомсыз […]
Елімізде COVID-19 инфекциясын 27 541 адам жұқтырды

ҚР Денсаулық сақтау министрлігі Ұлттық денсаулық сақтау ұлттық орталығының Жұқпалы аурулардың алдын алу департаментінің директоры Жұмабек Бекенов Қазақстан бойынша коронавирус инфекциясын жұқтырғандар жайлы мәлім етті, деп хабарлайды Елорда Инфо тілшісі. […]
Коронавирус: 30 мыңға жақындап қалдық

Нұр-Сұлтан, BAQ.KZ тілшісі. Денсаулық сақтау министрлігінің қоғамдық денсаулық сақтау ұлттық орталығы жұқпалы аурулардың алдын алу департаментінің директоры Жұмабек Бекенов елдегі коронавирусқа байланысты жағдайды айтты. Қазіргі таңда елімізде 27 541 адам […]
Қоғамдық денсаулық сақтау ұлттық орталығы ұжымын Медицина қызметкері күнімен құттықтады

Орталықтың 10 қызметкері жемісті еңбектері және денсаулық сақтау саласын дамытуға қосқан үлестері үшін лайықты марапаттарға ие болды. Мадақтау рәсімі биыл онлайн-режимінде өтті. Орталық директоры Дамир Көбжасаров әріптестерін кәсіби мерекемен құттықтай […]
Италия сарапшылары коронавирус инфекциясын емдеу тәжірибесімен бөлісті

17 маусымда COVID-2019 мәселелері бойынша Италия сарапшыларының ұйымдастыруымен бейнеконференцбайланыс өтті. Оған Қазақстан, Өзбекстан, Түркіменстан және Қырғызстан өкілдері қатысты. Шара барысында қатысушы елдердің сұрақтарына жауап берілді. Конференцбайланыс қатысушыларының арасында ҚР ДСМ […]
Өзара ынтымақтастық туралы меморандум жасалды

Маусым айының басында ҚР ДСМ Қоғамдық денсаулық сақтау ұлттық орталығында (ҚДСҰО) «Астана медицина университеті» КеАҚ (АМУ) өкілдерімен Денсаулық сақтау саласын дамытудың 2020-2025 жылдарға арналған мемлекеттік бағдарламасын (ДСДМБ) іске асыру мәселелерін […]
Қашықтан жұмыс істеу: тиімділікті қалай арттыруға болады?

Коронавирустың алдын алу мақсатында жұмыс берушілер қызметкерлерді қашықтан жұмыс істеуге ауыстырып жатыр. Көпшілік мұны сынақ ретінде қабылдауда. Үйден жұмыс істеу жағдайында тиімділікті қалай арттыруға болады? ҚР ДСМ Қоғамдық денсаулық сақтау […]
Салауатты өмір салтын ұстануда скандинав жүрісінің рөлі зор

Қазір қос таяқпен жаяу жүретін скандинав жүрісі (Nordic walking — норд немесе фин жүрісі) ең танымал спорт түрі болды. Скандинав жүрісі тиімді, жанға жайлы және кез келген жастағы адамдарға қолайлы, […]
Жақыныңа жанашыр бол: Коронавирустың симптомсыз түрін жұқтырған пациенттерге жадынама

НҰР-СҰЛТАН. ҚазАқпарат – Коронавирус инфекциясының симптомсыз түрі анықталған науқас амбулаториялық жағдайда медициналық бақылауға алынып, үйінде (үй карантині) оқшауланады. ҚазАқпарат назарларыңызға коронавирус инфекциясының симптомсыз түрі бойынша пациенттерге арналған жадынаманы ұсынылады. Үй […]